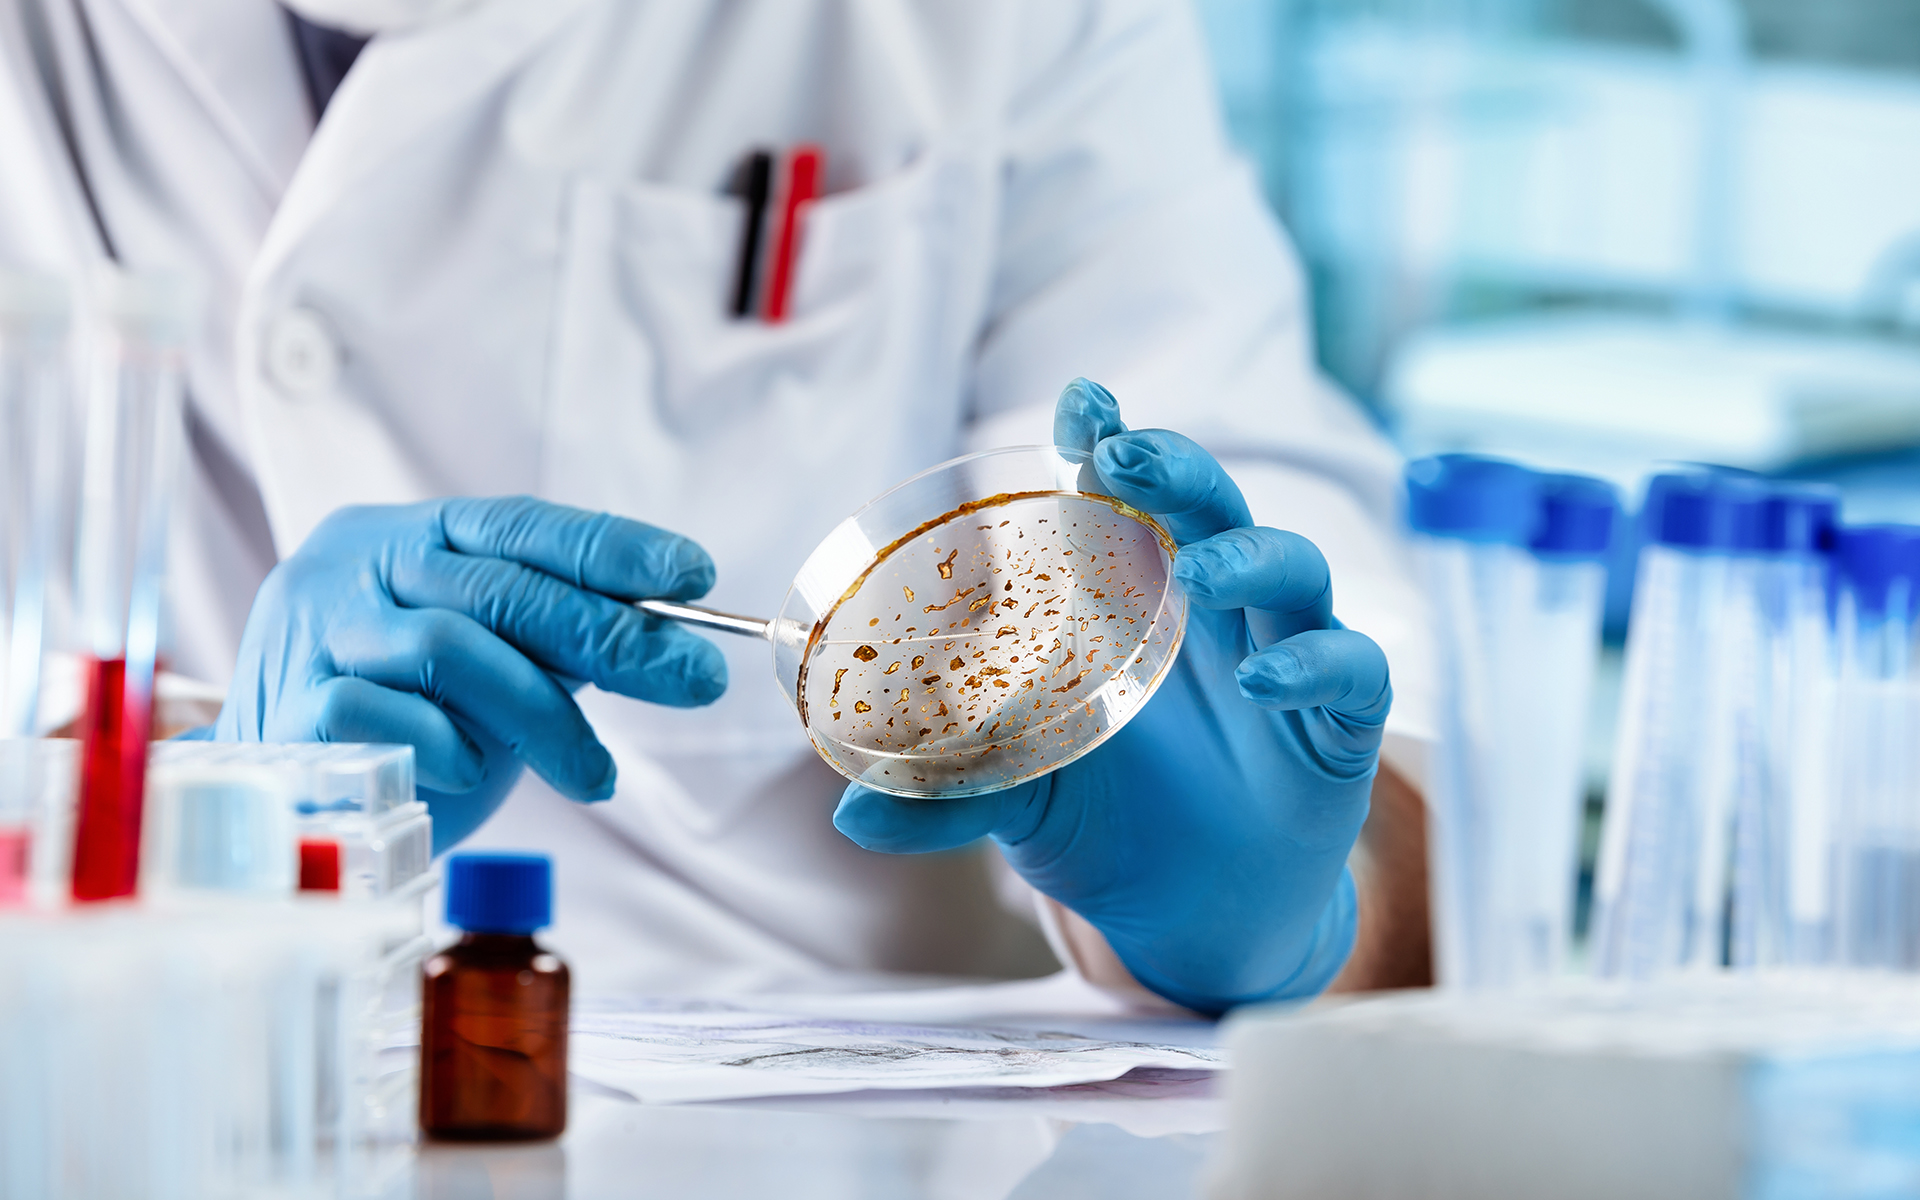

The Open Microbiology Journal is a peer-reviewed open-access journal that publishes research articles, reviews/mini-reviews, case studies, guest-edited thematic issues and short communications/letters covering theoretical and practical aspects of Microbial systematics, evolutionary microbiology, immunology, virology, parasitology , bacteriology, mycology, phycology, protozoology, microbial ecology, molecular biology, microbial physiology, biochemistry, microbial pathogenesis, host-microbe interaction, systems microbiology, synthetic microbiology, bioinformatics.
The Open Microbiology Journal, a peer-reviewed journal, is an important and reliable source of current information on developments in the field. Emphasis is placed on publishing quality papers, making them freely available to researchers worldwide.
The Open Microbiology Journal is an international, peer-reviewed, open-access journal covering all aspects of microbiology published continuously by Bentham Open.